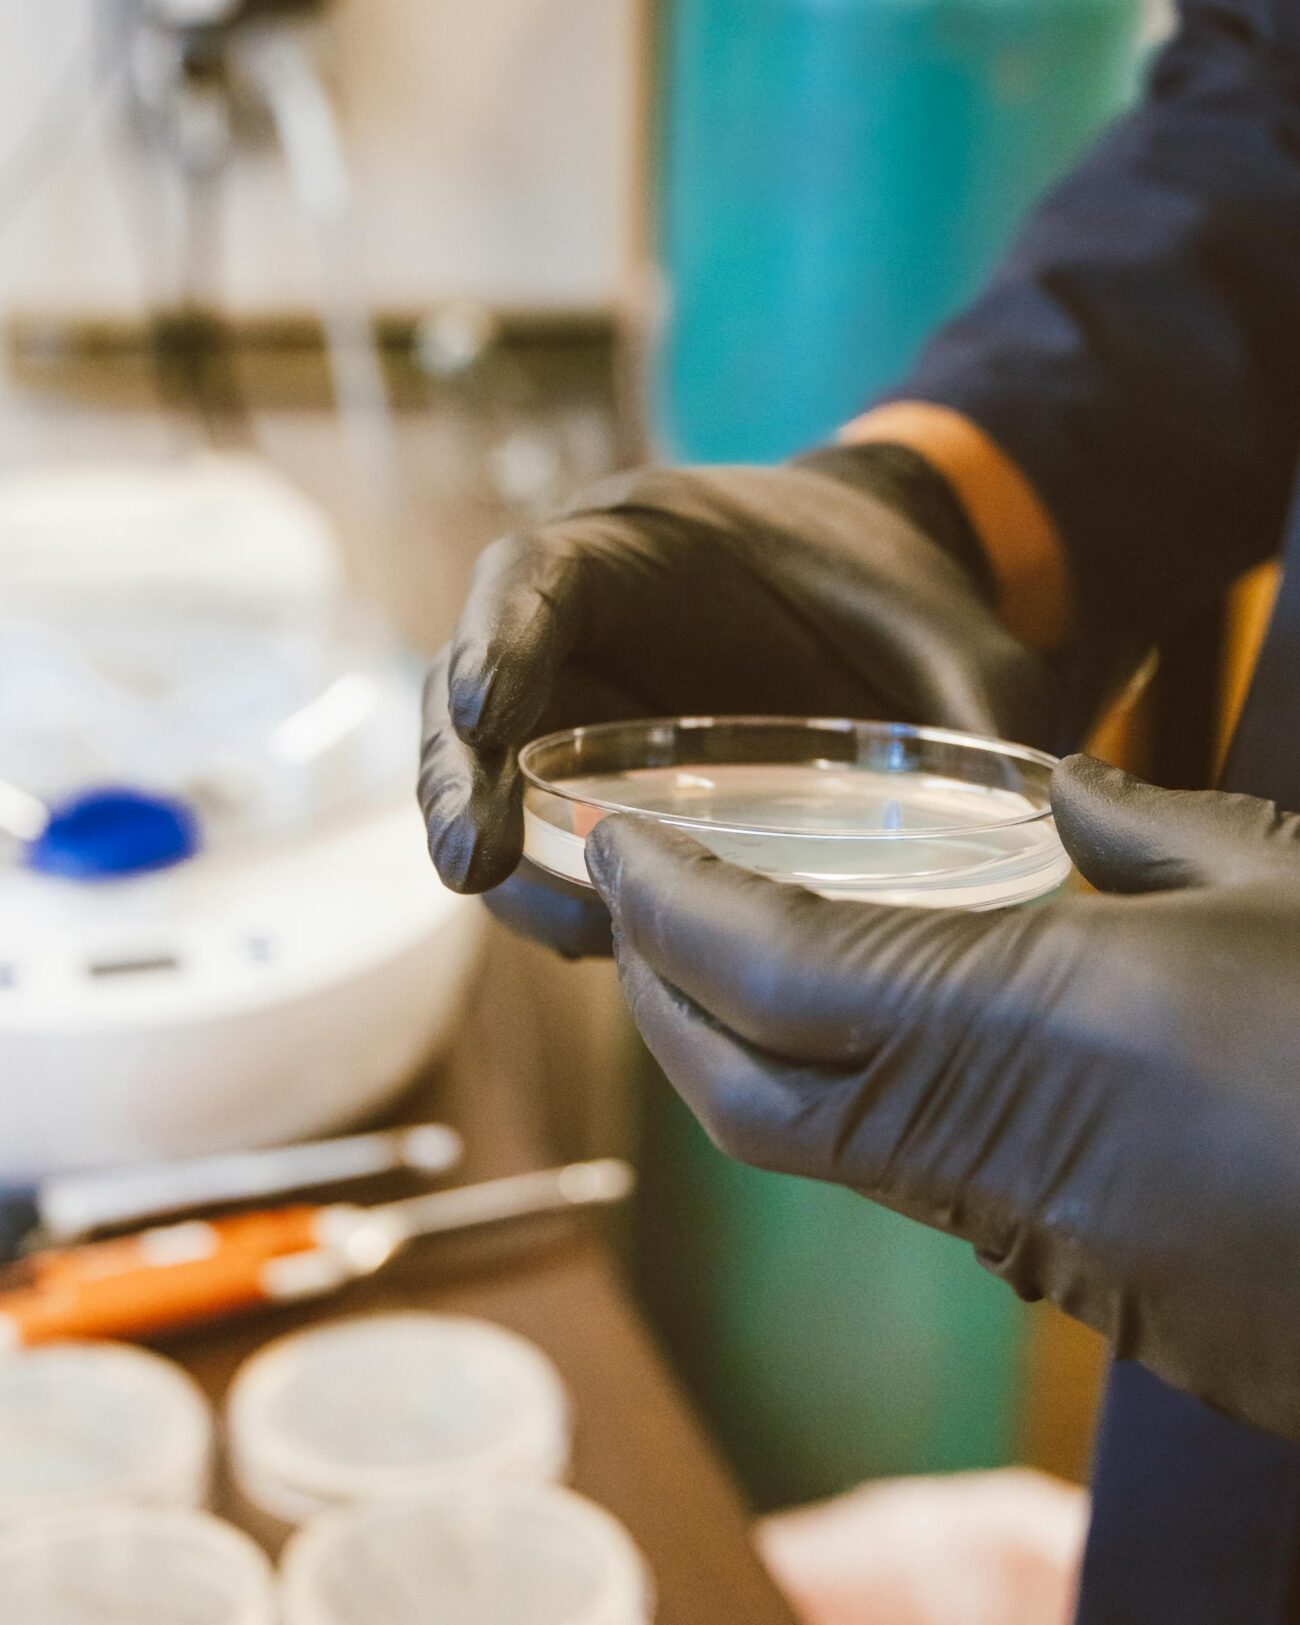

Phlebotomy Technician Training in Ohio
Get job-ready in 6 weeks with expert instruction, hands-on lab practice, and prep for national certification. Evening hybrid schedule available.
Get job-ready in 6 weeks with expert instruction, hands-on lab practice, and prep for national certification. Evening hybrid schedule available.
Get job-ready in 6 weeks with expert instruction, hands-on lab practice, and prep for national certification. Evening hybrid schedule available.

Phlebotomy technicians draw and process blood for testing, transfusions, research, and donations in hospitals, labs, blood centers, and physician offices. Our 6-week hybrid program blends classroom learning with supervised labs so you master safe, accurate blood collection and patient care.
What you’ll learn
Venipuncture and capillary collection
Order of draw, tube selection, labeling, and specimen integrity
Butterfly, vacutainer, and dermal puncture techniques
Infection control, PPE, OSHA/CLSI standards, and needlestick prevention
Difficult draws, special collections, and patient communication
Safety, quality assurance, and professionalism in clinical settings
Graduate ready to pursue certification and entry-level roles across hospitals, diagnostics labs, and outpatient clinics.
See requirements below.
18 years of age or older
Submit a copy of high school diploma or GED transcript
Proficiency in English reading, writing, and comprehension
Submit a photo ID and Social Security card
Physical and TB screening
Pass a criminal background check
Must sign consent/participation forms for lab practice
Upcoming 2025 Schedule
No additional 2025 start dates are currently scheduled.
Standard HYBRID format: 6 weeks, Tuesdays and Thursdays, 5:30 PM–9:00 PM.
Service areas: Cleveland • Akron • Youngstown • Warren • Cincinnati
Program Fees
Cincinnati: $775 – $200 deposit required to hold your seat
Cleveland / Youngstown / Warren: $725 – $200 deposit required to hold your seat
Register Below
If applying for financing, please include $200 for study materials and exam certification. Enrollment is confirmed when your deposit is received. An admissions advisor will contact you with next steps.
Our courses offer smaller class sizes, one on one attention, flexible schedules, and online options. See below for more information on our courses and to register!. Our school is certified to teach varies of different Allied Health Courses and approved by ODH for our Nurse Aide Training Course.
COVID Tests and Screens may be conducted on all students that enter our Lab and/or Clinical Site. If a student tests positive for COVID 19, 1st Choice Career Centers will follow CDC recommended guidelines and the positive student may be placed on hold from attending in-person classes and the hold duration will be based on CDC recommendations.
Address: 4767 Northfield Rd., North Randall, Ohio 44128
Phone: 216-230-9245
SMS: 440-263-6120
Email: firstchoicecareercenter22@gmail.com
Business Hours: Monday – Thursday, 10:00 AM – 3:00 PM
Address: 8505 Reading Rd., Suite B, Cincinnati, Ohio 45215
Phone: 216-230-9245
SMS: 440-263-6120
Email: firstchoicecareercenter22@gmail.com
Business Hours: Monday – Thursday, 10:00 AM – 3:00 PM
Address: 5836 Youngstown Warren Rd., Niles, Ohio 44446
Phone: 216-230-9245
SMS: 440-263-6120
Email: firstchoicecareercenter22@gmail.com
Business Hours: Monday – Thursday, 10:00 AM – 3:00 PM
Address
4767 Northfield Rd., North Randall, Ohio 44128
Phone
216-230-9245
SMS
440-263-6120